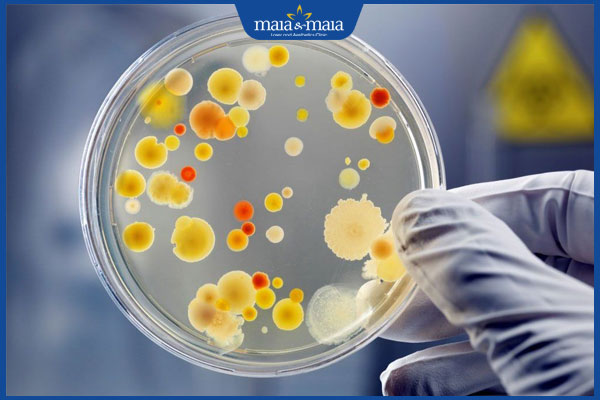
chiết xuất enzyme

Peel da sinh học là phương pháp làm đẹp cải thiện được nhiều vấn đề về da, tuy nhiên có nên thực hiện phương pháp này không? Hiệu quả và quy trình thực hiện thế nào? Cùng tìm hiểu thêm về phương pháp peel da sinh học qua bài viết sau của Hệ thống Phòng khám Da liễu Thẩm mỹ Maia&Maia.
I. Tìm hiểu về phương pháp peel da sinh học
1. Peel da sinh học là gì?
Peel da sinh học là phương pháp sử dụng các hoạt chất hóa học nhẹ có chứa chiết xuất thiên nhiên tác động lên thượng bì làn da để giúp da đều màu, loại bỏ những tế bào da cũ và kích thích sản sinh tế bào da mới để giúp da trẻ hóa, xóa mờ nếp nhăn, da sáng đều màu hơn.
2. Hoạt chất thường dùng trong peel sinh học
Có rất nhiều hoạt chất hóa học được sử dụng để thực hiện peel da sinh học. Dưới đây là những hoạt chất chính:
- Enzyme trái cây: Dùng các enzyme trái cây chiết xuất từ đu đủ, dứa để peel da nhẹ nhàng, loại bỏ tế bào chết, thích hợp với làn da nhạy cảm.
- Chiết xuất thảo dược: Peel da sinh học với chiết xuất từ cam thảo, trà xanh, cúc la mã, lô hội, nghệ, tảo biển,…giúp loại bỏ tế bào chết cũ, làm dịu và sáng da tự nhiên nhẹ nhàng
- Axit hữu cơ nhẹ: Phương pháp tẩy tế bào chết, tái tạo làn da dùng acid có nguồn gốc tự nhiên (trái cây, sữa, thảo dược) nồng độ thấp như Lactic Acid, Mandelic Acid, Malic Acid, Citric Acid, Tartaric Acid,…
3. Phân biệt peel da sinh học và hóa học
Peel da sinh học và hóa học có những đặc điểm khác nhau để mọi người phân biệt, chi tiết như sau:
| Peel da sinh học | Peel da hóa học | |
| Thành phần | Tẩy tế bào chết với chiết xuất tự nhiên (enzyme, acid hữu cơ từ trái cây, thảo dược) | Tẩy tế bào chết sử dụng acid hóa học, acid mạnh (TCA, Salicylic. Glycolic,…) tái tạo làn da. |
| Cơ chế | Giúp làm mềm da, loại bỏ tế bào chết da nhẹ nhàng, kích thích da tái tạo tự nhiên | Phá vỡ các tế bào sừng, gây ra bong tróc da mảng lớn để kích thích tái tạo da |
| Mức độ xâm lấn | Nhẹ, nông | Nhẹ đến mạnh (tùy theo nồng độ hoạt chất sử dụng) |
| Thời gian phục hồi | Gần như không có, bong tróc da ít | Tùy mức độ peel, thường từ 1 – 3 tuần |
| Tác dụng phụ | Dịu nhẹ, ít kích ứng | Da dễ kích ứng, bong tróc, đỏ rát, cần phục hồi và chăm sóc kỹ |
| Đối tượng phù hợp | Người có da yếu và nhạy cảm, mới bắt đầu peel da muốn làm sáng da, dịu da, dưỡng ẩm và thanh lọc da nhẹ | Người có làn da khỏe, da dày không có bệnh lý về da, thích hợp cho người bị mụn nám, thâm sẹo, da lão hóa nhẹ |
II. Ưu và nhược điểm của peel da sinh học
Peel da sinh học cũng giống như nhiều phương pháp làm đẹp làn da khác có ưu/nhược điểm riêng, chi tiết như sau:
Ưu điểm
- Loại bỏ nhanh những tế bào tổn thương dịu nhẹ, ít kích ứng
- Phương pháp có thể áp dụng thường xuyên
- Phù hợp với nhiều làn da, kể ra da mỏng yếu và nhạy cảm

Nhược điểm
- Hiệu quả tác dụng chậm, cần thời gian lâu dài
- Chỉ phù hợp với làn da ít khuyết điểm, da không đều màu, da khô, nếp nhăn nhẹ.
- Cần thực hiện đúng cách, ưu tiên chọn bác sĩ và cơ sở y tế uy tín để tránh tổn thương da
- Chăm sóc sau peel da đúng cách bởi sau peel da sinh học da rất nhạy cảm.
BẠN NÊN BIẾT: Peel da để qua đêm được không?
III. Các trường hợp không nên peel da sinh học
Peel da sinh học là phương pháp làm đẹp da an toàn tuy nhiên không phải trường hợp nào cũng phù hợp áp dụng phương pháp. Dưới đây là những trường hợp không nên thực hiện:
- Da đang có vết thương hở, nhiễm trùng, mắc bệnh ngoài da mãn tính (vảy nến, viêm da cơ địa, lupus,…)
- Người có cơ địa dễ bị sẹo xấu.
- Người đang dùng Isotretinoin và các loại thuốc điều trị gây nhạy cảm với ánh sáng.
- Phụ nữ mang thai và đang cho con bú.

IV. Quy trình peel da sinh học chuẩn y khoa
Peel da sinh học chuẩn y khoa cần đảm bảo đúng quy trình để hiệu quả của phương pháp được tối ưu. Dưới đây là chi tiết quy trình peel da sinh học để mọi người tham khảo:
- Bước 1: Vệ sinh sạch làn da: Dùng tẩy trang và sữa rửa mặt để loại bỏ bụi bẩn ở làn da, tránh nhiễm khuẩn khi peel da
- Bước 2: Chụp ảnh lưu hồ sơ: Trước khi điều trị chuyên sâu khách hàng sẽ chụp ảnh nhiều góc mặt để lưu hồ sơ, theo dõi sự thay đổi khi peel da
- Bước 3: Chuẩn bị dụng cụ: Các kỹ thuật viên sẽ thực hiện chuẩn bị những dụng cụ và hoạt chất peel đúng theo chỉ định bác sĩ, đảm bảo vô khuẩn tuyệt đối.
- Bước 4: Bôi thoa Bepanthen: Bepanthen được bôi lên những vùng da nhạy cảm như quanh mắt, khóe miệng, khóe mũi để bảo vệ da khỏi những hoạt chất peel sinh học.
- Bước 5: Thực hiện peel da sinh học: Hoạt chất peel được thoa lên trên da, trung hòa dung dịch nếu cần thiết. Sau đó loại bỏ hoạt chất peel đúng thời gian, tránh để quá lâu trên da.
- Bước 6: Vệ sinh sạch da, làm dịu da: Da mặt được vệ sinh sạch với nước lạnh, chườm lạnh để làm dịu da. Ngoài ra sẽ dùng thêm các sản phẩm dưỡng để cân bằng và tạo độ ẩm cho da.
- Bước 7: Hẹn lịch tái khám, hướng dẫn chăm sóc: Các kỹ thuật viên, bác sĩ sẽ hẹn lịch tái khám kiểm tra hiệu quả, hướng dẫn khách hàng cách chăm sóc làn da sau peel để nhanh phục hồi.

V. Peel da sinh học giá bao nhiêu?
Peel da sinh học hiện nay có mức giá từ 500.000 VNĐ – 3.000.000 VNĐ/lần thực hiện. Mức giá này sẽ còn tùy thuộc vào nhiều yếu tố như địa chỉ thực hiện, tay nghề bác sĩ, tình trạng làn da, hoạt chất peel và liều lượng sử dụng, chương trình ưu đãi cũng như khu vực, thời điểm peel da.
VI. Những lưu ý quan trọng khi peel da sinh học
Peel da sinh học là phương pháp cải thiện làn da nhanh chóng tuy nhiên cần chú ý những vấn đề sau để đảm bảo hiệu quả phương pháp, giúp da nhanh phục hồi:
1. Trước khi thực hiện peel da
- Tìm hiểu kỹ địa chỉ peel da uy tín và tham khảo ý kiến bác sĩ để đánh giá tình trạng da, lựa chọn hoạt chất và cấp độ peel phù hợp.
- Đảm bảo sản phẩm peel có nguồn gốc rõ ràng, đã được kiểm định an toàn để tránh rủi ro cho da.
- Cân nhắc chi phí dịch vụ, vì da mụn nhẹ/xỉn màu sẽ có mức giá thấp hơn so với da nám/sẹo cần peel chuyên sâu.
- Dừng sử dụng AHA, BHA, Retinoids, Vitamin C nồng độ cao, Benzoyl Peroxide để tránh kích ứng và làm da nhạy cảm sau peel.
- Che chắn cẩn thận, tránh để da bị bỏng hoặc cháy nắng trước khi thực hiện peel.

2. Cách chăm sóc da sau khi peel da sinh học
Sau peel da sinh học da sẽ đỏ nhẹ, ngứa rát, nổi mẩn. Sau đó vài ngày, da khô sạm đi và bong tróc nhẹ. Bởi vậy giai đoạn sau khi peel, mọi người cần chăm sóc đúng cách làm dịu và giúp da nhanh phục hồi, chi tiết như sau:
- Vệ sinh sạch da nhẹ nhàng, trong 6 – 8 tiếng đầu sau peel da nên rửa mặt với nước mát, nước muối sinh lý. Mọi người tránh dùng các sản phẩm tẩy tế bào chết, sữa rửa mặt, mỹ phẩm trang điểm để tránh da sau peel viêm nhiễm
- Dưỡng ẩm và phục hồi da với kem dưỡng/serum có chứa những thành phần như vitamin B5, Ceramide, Hyaluronic Acid.
- Bảo vệ da khỏi ánh nắng, dùng kem chống nắng hàng ngày SPF 50+ và che chắn kỹ làn da nếu phải ra ngoài.
- Trong 3 – 7 ngày sau khi peel da sinh học nên tránh dùng những hoạt chất mạnh như AHA, BHA, Vitamin C nồng độ cao, Retinoids.
- Không xông hơi, massage, spa chăm sóc da mặt trong 2 – 3 ngày đầu sau peel.
- Tránh sờ chạm, tự ý bóc mảng da bong tróc sau peel bởi dễ khiến da tổn thương, để lại sẹo, bên để cho da bong tróc tự nhiên.
- Cải thiện và phục hồi làn da với chế độ ăn lành mạnh với nhiều vitamin và khoáng chất (rau xanh, trái cây), thực phẩm chứa Omega 3, kẽm giúp da nhanh phục hồi.
- Luôn ngủ nghỉ đúng giờ, hạn chế thức khuya, kiểm soát căng thẳng với các hoạt động vận động nhẹ như yoga, thiền định, không vận động mạnh để tránh tăng tiết mồ hôi khiến da sau peel viêm nhiễm.
- Theo dõi tình trạng làn da, nếu thấy da có những biểu hiện bất thường như ngứa rát kéo dài, da nổi mụn nước, sưng tấy và có mủ thì nên nhanh chóng thăm khám và điều trị với các bác sĩ da liễu.
Peel da sinh học sẽ giúp làm đều màu da, giảm mụn nám nhẹ, cải thiện nếp nhăn nông nếu thực hiện kỹ thuật, chăm sóc da đúng cách. Nếu có nhu cầu tư vấn thêm về các phương pháp làm đẹp da với công nghệ cao liên hệ ngay với Thẩm mỹ Maia&Maia qua hotline 032.845.1188

